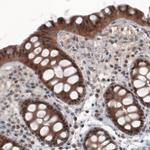
PGM1 Antibody in Immunohistochemistry (Paraffin) (IHC (P))

Search
Invitrogen
PGM1 Monoclonal Antibody (CL3299)
{{$productOrderCtrl.translations['antibody.pdp.commerceCard.promotion.promotions']}}
{{$productOrderCtrl.translations['antibody.pdp.commerceCard.promotion.viewpromo']}}
{{$productOrderCtrl.translations['antibody.pdp.commerceCard.promotion.promocode']}}: {{promo.promoCode}} {{promo.promoTitle}} {{promo.promoDescription}}. {{$productOrderCtrl.translations['antibody.pdp.commerceCard.promotion.learnmore']}}

Please note: We are reviewing Western blot images included in the antibody testing data in our catalog, including those provided by third parties. Unless expressly labeled or annotated as “raw-unedited”, Western blot images included in the antibody testing data in our catalog may have been edited, optimized or otherwise adjusted for presentation.
产品信息
MA5-24653
种属反应
宿主/亚型
分类
类型
克隆号
抗原
偶联物
形式
浓度
规格
纯化类型
保存液
内含物
保存条件
运输条件
RRID
产品详细信息
Immunogen sequence: SILATRKQSV EDILKDHWQK HGRNFFTRYD YEEVEAEGAN KMMKDLEALM FDRSFVGKQF SANDKVYTVE KADNFEYSD
Highest antigen sequence identity to the following orthologs: Mouse - 97%, Rat - 97%.
Binds to an epitope located within the peptide sequence HGRNFFTRYD as determined by overlapping synthetic peptides.
靶标信息
Phosphoglucomutases (PGM; EC 5.4.2.2) catalyze the transfer of phosphate between the 1 and 6 positions of glucose. Isozymes of PGM are monomeric, with molecular masses of about 60 kD, and are encoded by several genes, including PGM1. In most cell types, PGM1 isozymes predominate, representing about 90% of total PGM activity. One exception is red cells, where PGM2 (MIM 172000) is a major isozyme (Putt et al., 1993 [PubMed 8257433]). [supplied by OMIM].
仅用于科研。不用于诊断过程。未经明确授权不得转售。
篇参考文献 (0)
生物信息学
蛋白别名: ARABIDOPSIS THALIANA PHOSPHOGLUCOMUTASE; ATPGMP; Glucose phosphomutase 1; MIO24.4; MIO24_4; PGM; PGM 1; PGM1; PHOSPHOGLUCOMUTASE; Phosphoglucomutase-1; STARCH-FREE 1; STF1
基因别名: PGM1
Entrez Gene ID: (Human) 5236



